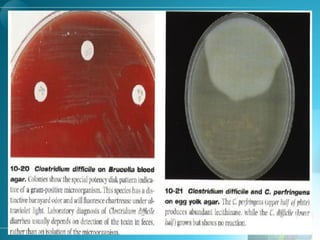
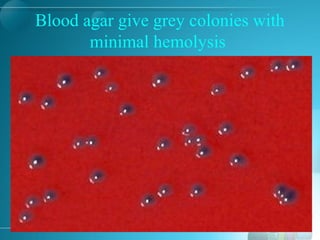
Blood agar give grey colonies with
minimal hemolysis

Clostridium perfringens is a gram-positive, anaerobic, spore-forming rod that can cause gas gangrene and food poisoning in humans. It produces several toxins including alpha toxin, which lyses cells, and an enterotoxin that causes diarrhea. C. perfringens has four major types (A-D) defined by their toxin production. Type A is the most common cause of human disease. It forms double zones of hemolysis on blood agar and shows a positive Nagler reaction. Clinical manifestations include gas gangrene characterized by tissue necrosis and food poisoning presenting with diarrhea. Diagnosis involves culture and identification of toxin production.